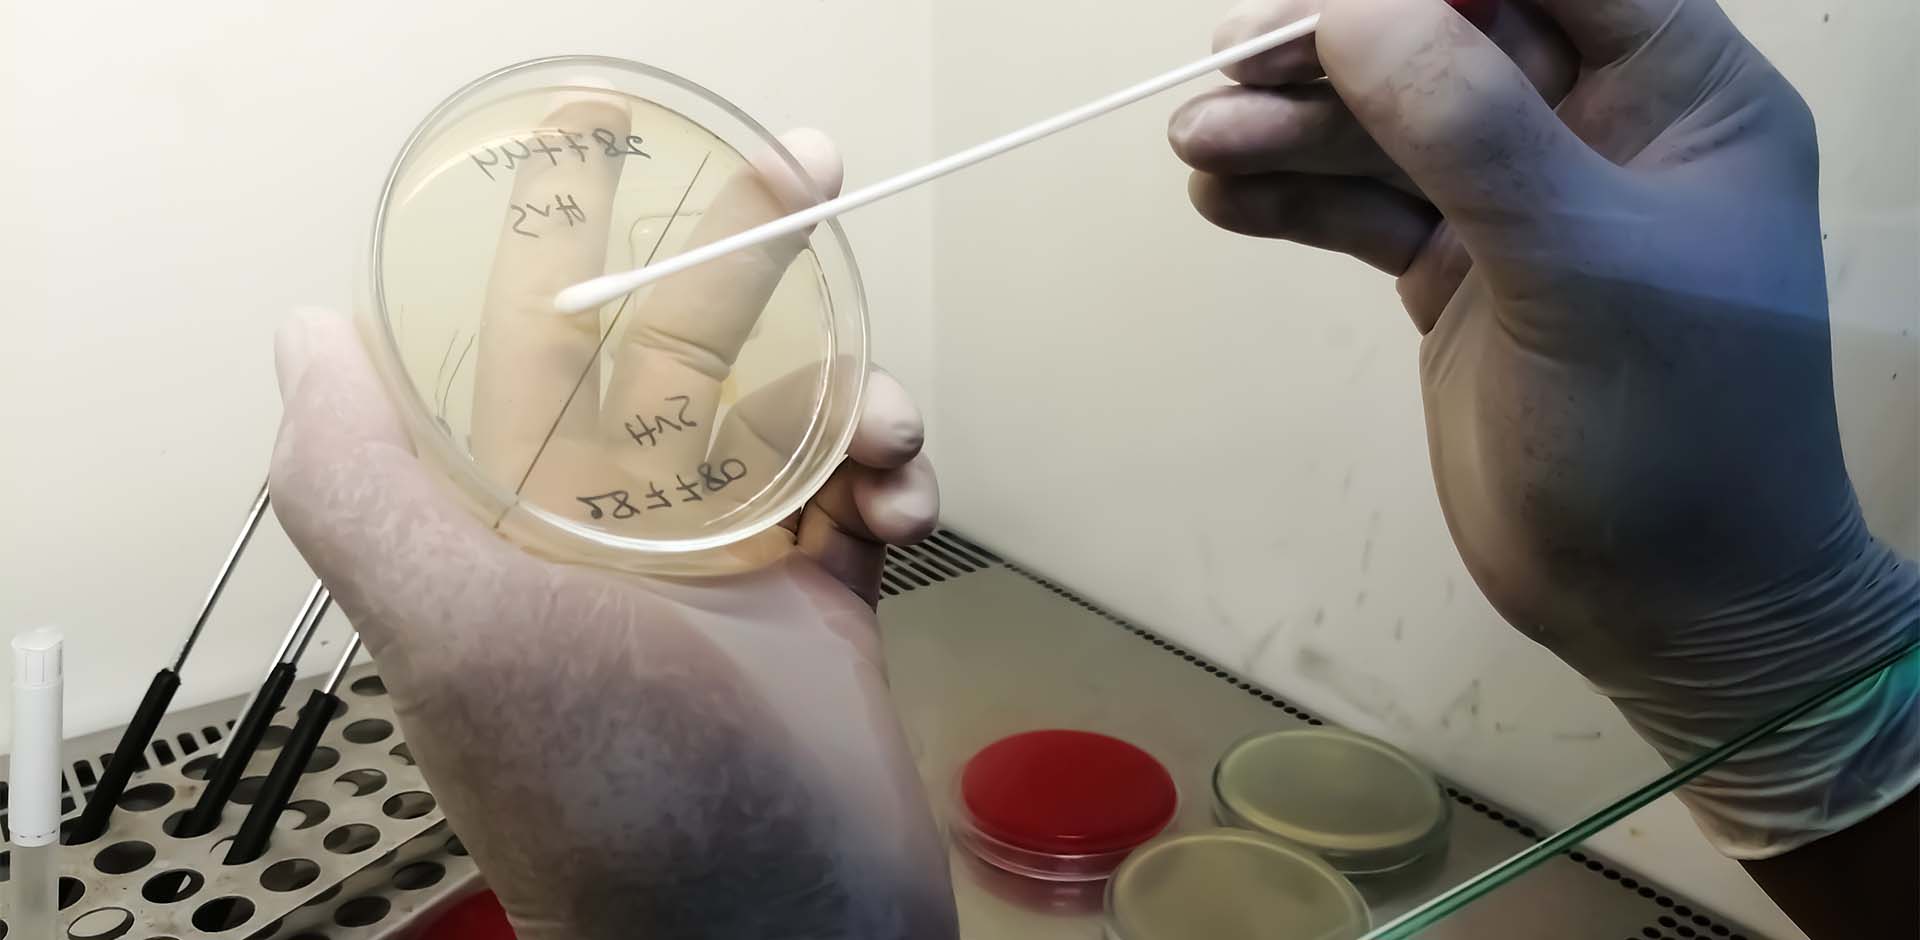

About US
Demand driven research on oil palm and coconut
The Institute has the mandate to research on oil palm and coconut and is tasked to conduct sustainable and demand driven research aimed at providing scientific and technological support for the development of the entire oil palm and coconut industries.
Research
Our Research Programmes
The CSIR-OPRI has two commodity programmes namely; the Oil Palm and Coconut Programmes. The Oil Palm Programme is located at Kusi, near Kade in the Denkyembour District of the Eastern Region whilst the Coconut Programme is located at Sekondi-Takoradi in the Western Region. The Institute’s current out-stations are located at Agona-Nkwanta in the Ahanta-West District of the Western and Asebu in the Asebu-Amenfi-Kwamankese (AAK) District of the Central Region.
Oil Palm Programme

Oil Palm Programme
The programme has over 50 years of research experience in oil palm and has built the capacity and developed a cream of Research Scientists, Technologists and Technicians for consultancy and training in oil palm nursery, establishment and management in Ghana and in the rest of Africa.
Learn more Coconut Programme

Coconut Programme
The Coconut Programme has been designated as the leader in lethal yellowing (LY) research in Africa by the Bureau for the Development of Research on Tropical Perennial Oil Crops (BUROTROP).The Programme has developed several cutting edge technologies to manage the devastating......
Services
Consultancy & Training Services
With over 50 years of research into oil palm and more than 25 years in coconut research the Institute has built the capacity and developed a cream of Research Scientists, Technologists and Technicians for providing training services in oil palm and coconut.
Consultancy services are provided to clients of all categories in the following areas;
- Feasibility studies,
- Plantation valuation,
- Phytosanitary monitoring,
- Soil fertility testing and fertilizer requirements,
- Contract research,
- Technical services for plantation establishment & Management,
- Technical services for oil palm and coconut value Addition
Over the years we have developed several technologies which are called research developed products. These products as well as technical guides are available for sale at our offices. Please contact us for your orders.
Sale of coconut and oil palm seedlings
We have available large quantities of Hybrid coconut seedlings as well as High yielding tenera oil palm seedlings for sale. These are high yielding seedlings developed by our seasoned scientists.
Sale of Fresh fruit oil palm bunches
We also have Fresh fruit palm bunches for sale. These fruits are fresh from our farms.
Technical Guides
We have available Quality Palm Oil Processing Guide, and Oil Palm Management Practices Field Guide for sale. You can get copies of these guides at our office. Kindly contact us for your copies.
With over 50 years of research into oil palm and more than 25 years in coconut research the Institute has built the capacity and developed a cream of Research Scientists, Technologists and Technicians for providing training services in oil palm and coconut as detailed in the training programme below. The CSIR-OPRI also organizes customized training programmes to address specific needs of individuals, organizations/ institutions either local or international.
We Provide Expert Training in
We Provide Expert Training in
- Best Practices in Oil Palm Nursery Establishment and Management
- Best Agronomic Practices in Oil Palm Plantation Establishment and Management.
- Best Practices in Oil Palm Pest and Disease Management.
- Best Practices in Quality Palm Oil Processing
- Best Practices in Coconut Nursery Establishment & Management.
- Best Agronomic Practices in Coconut Plantation Establishment and Management.
- Best Practices in Coconut Pest & Disease Management.
- Best Practices in Quality Coconut Oil Processing.
Facts
Our Achivements
Over The Years
We have achieved a lot together as an Institute. We continue to work hard to maintain our standards and professionalism.
0
Years of Experience
0
Satisfied Clients
0
Scientists
0
Successful Projects
Accomplishment
Achievements & Awards
CSIR-OPRI is designated as the leader in lethal yellowing (LY) research in Africa by the Bureau for the Development of Research on Tropical Perennial Oil Crops (BUROTROP). The Institute has developed several cutting-edge technologies to manage the devastating lethal yellowing disease of coconut. These include the development of a tolerant hybrid to the disease in Ghana. An environmentally friendly and non-polluting cultural practice that slows down/contain the spread of LY in disease endemic areas. The technology helps to prolong the productive life of plantations in the face of Lethal Yellowing Disease.
Projects
Our Research Projects
Our research and development projects has contributed positively to the socio-economic development of the nation.